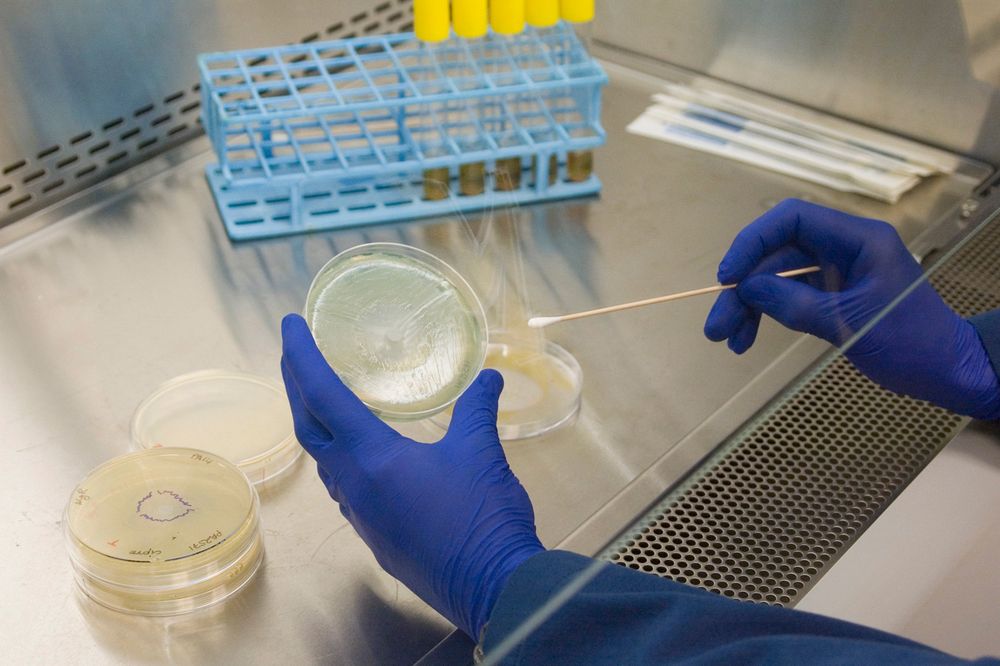

Ahol a kéz, ott a fertő
Antibakteriális bevonatot fejleszt a Ford
Ez a cikk több mint 90 napja frissült utoljára, ezért kérjük, az olvasása során ezt vegye figyelembe!
A Ford kutatói a michigani egyetemmel kooperálva megvizsgálták, hogy az autó utasterének mely részein legjelentősebb a szennyezettség.
Leginkább a kormányon és a középkonzolon, a pohártartók környékén lakoznak a bacilusok
Ahol a kéz, ott a fertő, ott tenyésznek a csúnya bacilusok - állapította meg az a vizsgálat, amelyet a Ford kutatócsoportja végzett a michigani egyetem együttműködésével. A legaggasztóbb a helyzet a pohártartók környékén és a kormányon. A jó kis zsíros szennyeződések, lerakódások ugye kiváló táptalajul szolgálnak a mikroorganizmusok számára. A kutatás célja persze nem az volt, hogy rámutassanak: koszosak vagyunk (eszünk-iszunk-dohányzunk-gusztustalankodunk, élünk a kocsiban), hanem Fordék csak egy első lépésnek szánták a megtisztulás útján. A következőkben igyekeznek olyan műanyagot, olyan bevonatot fejleszteni, amelynek láttán a gombák fejvesztve menekülnek, s nem tudnak megtelepedni. Segítségül az agiont hívják, ami egy környezetbarát, hosszú élettartamú, a kellemetlen szagok kialakulását is megakadályozó antibakteriális anyag. Drukkolunk.